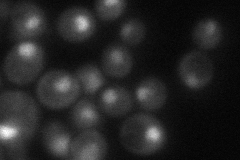
YMR125W

View description
Large subunit of the nuclear mRNA cap-binding protein complex, interacts with Npl3p to carry nuclear poly(A)+ mRNA to cytoplasm; also involved in nuclear mRNA degradation and telomere maintenance; orthologous to mammalian CBP80
Localization:
Intensity:
Fold change:
Significance:
-
C’ GFP library in SD

nucleus58.05 -
N' NOP1pr-GFP in SD

nucleolus104.745 -
N' TEF2pr-mCherry in SD

nucleus143.748 -
N' NATIVEpr-GFP in SD
nucleus50.5252 -
N' TEF2pr-VC and Cyto-VN in SD

#N/A0 -
C’ GFP library in SD+DTT

nucleus54.560.93No -
C’ GFP library in SD+H2O2

nucleus62.681.07No -
C’ GFP library in Starvation Media

nucleus54.780.94No -
C’ GFP library on the background of Pup2-DaMP

nucleus -
C’ GFP library on the background of CCT mutant

nucleus68.4081.17839No
